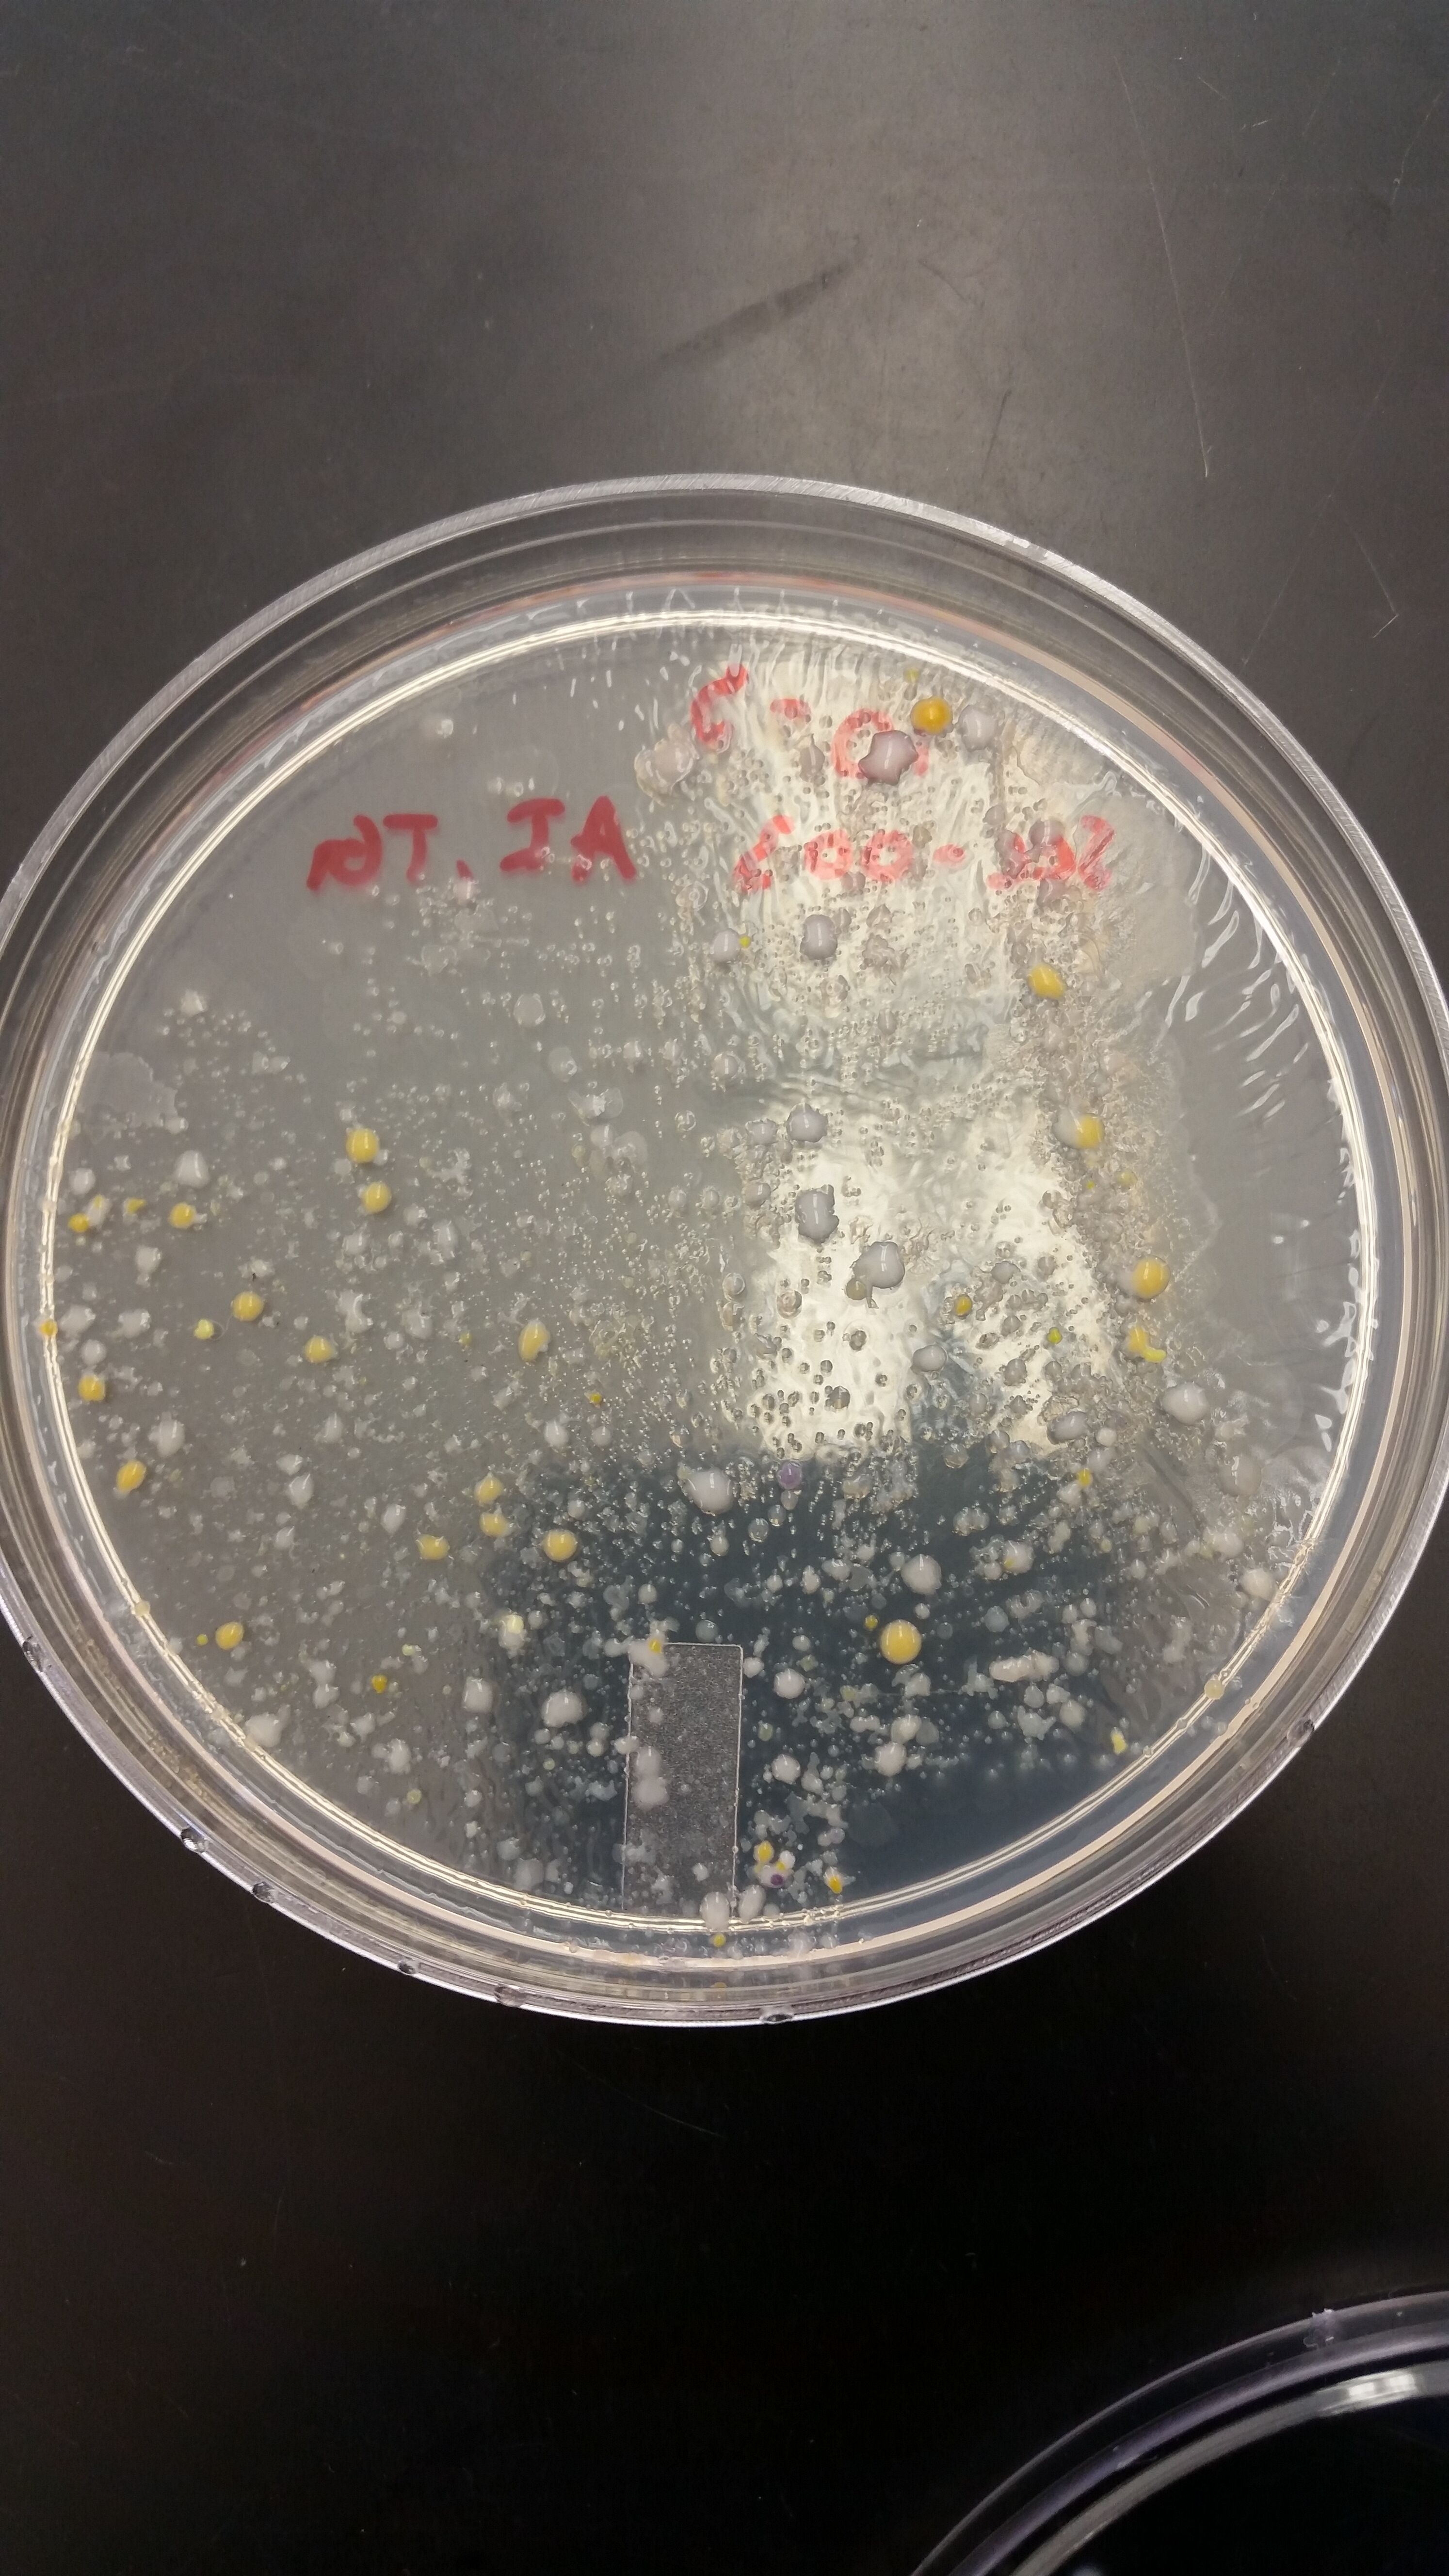
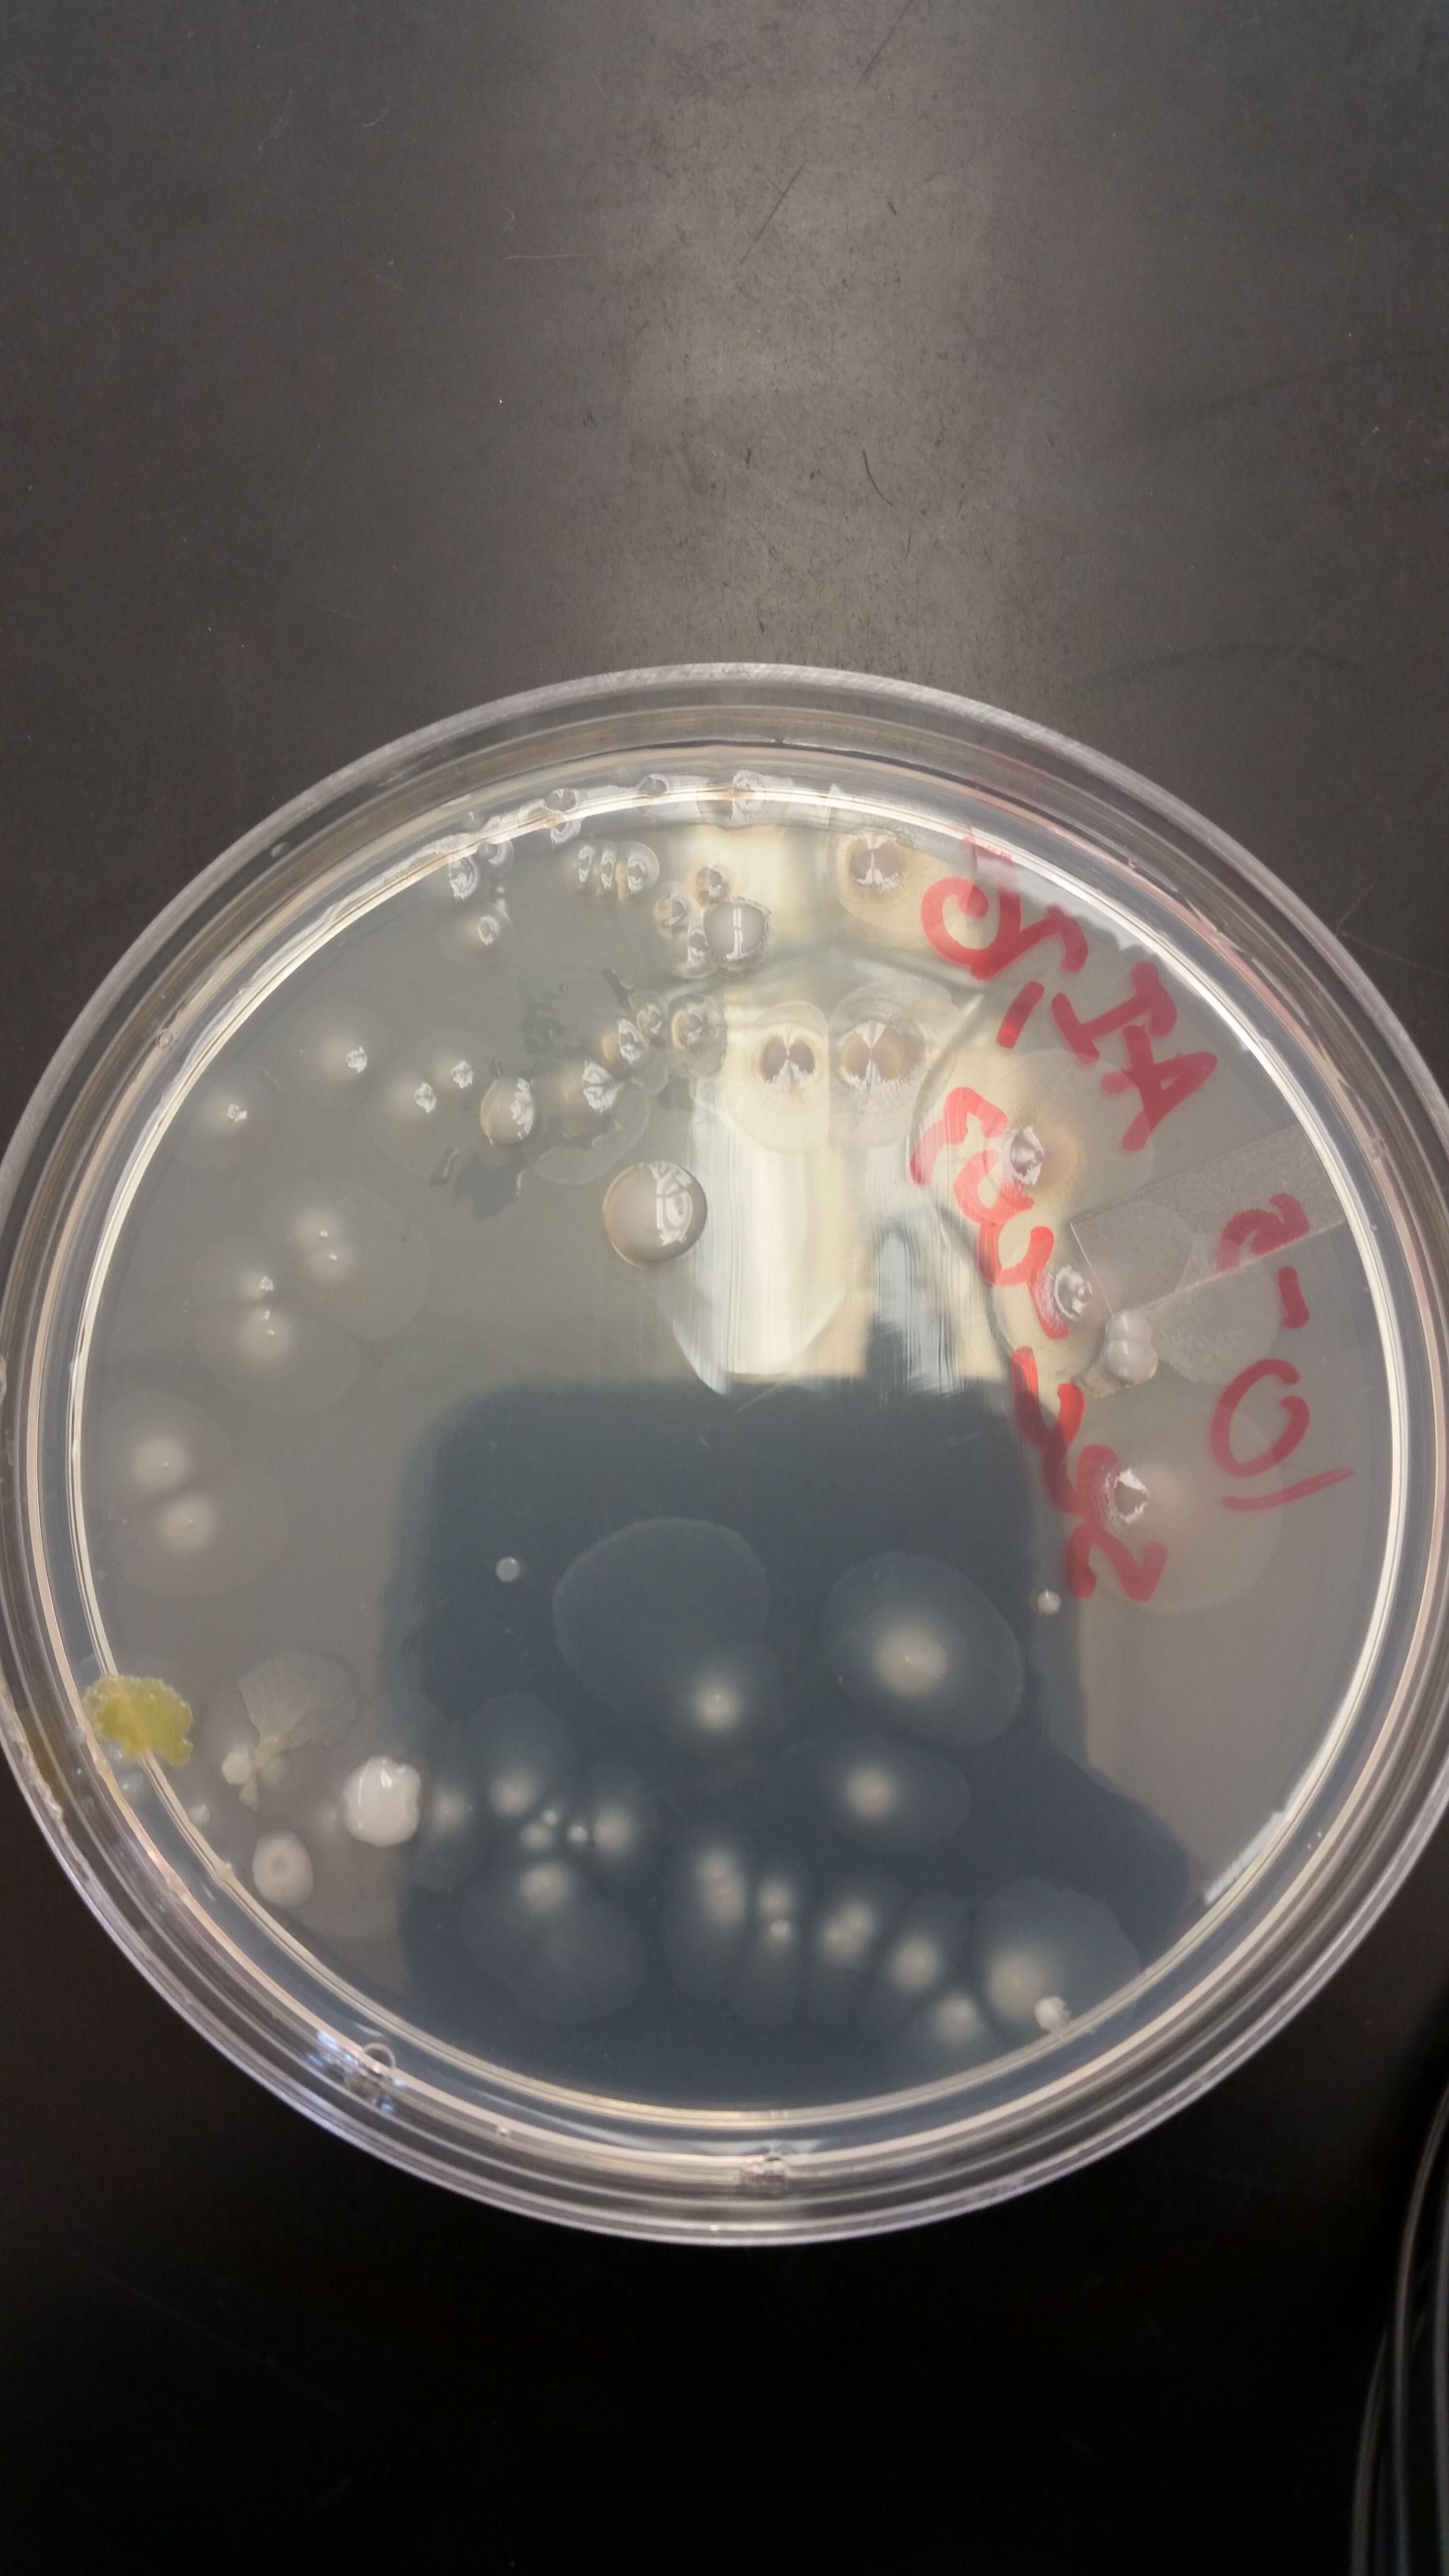

User:Allen D. Irving/Notebook/Biology 210 at AU
Zebrafish Development
Purpose
The purpose of this experiment was to see the effects ethanol has on the growth and development of zebrafish, from fertilized egg to a developed adolescent.
Materials and Methods 48 fertilized eggs were taken and separated into two groups of 24. Each group of eggs were then placed in individual plastic wells. The control group of 24 had their wells filled with water mixed with a anti-fungal agent, and the experimental group's wells were filled with a 1% Ethanol solution. For the next 2 weeks, the differences in development between the two groups was monitored, including stage of development, body size, color, and motility/responsiveness. At the 1 week point of the experiment when each fish had hatched and used up the rest of their yolk for energy, the fish were fed a shrimp brine solution.
Results There was not a huge difference in size or developmental stage between the control and experimental groups. Early on, the control had slightly more survivors after one week, though the difference was minimal. The most striking difference was the the experimental group developed to be noticeably more slender, with a yellow tint to their body. Other notable delineations include a "bend" in the bodies of the experimental group, where when they would stop, their bodies would contort slightly. The biggest variation from the control group was the the fish in the 1% Ethanol solution were hypermobile, where they would dart around their respective well, and would "shake" when still.
Discussion When looking at existing research, it seems that the 1% solution was not strong enough to severely affect the zebrafish development. One possible explanation for the hyper-mobility of the experimental fish could be some sort of withdrawal symptoms, though this is a tentative conclusion, since the wells were refilled every other day. More research should be done to look at prolonged exposure to ethanol.
- Allen D. Irving 10:51, 17 March 2016 (EDT):
PCR DNA Sequence from Transect
Purpose
A sample was taken from the agar plates containing the bacterial colonies collected from the Hay Infusion and run through a PCR machine to help determine the DNA sequence of any potential bacteria or other organisms that may be present in the transect.
Materials and Methods
The samples that were taken in lab were sent out to a third party for analysis. If there was an incomplete sequence or failed attempt, a successfully found sequence from the same transect by a prior group was used. The DNA was then run through the National Library of Medicine's blast website to find a closely matching sequence.
Results and Discussion
Found DNA Sequence
NNNNNNNNNNNNNNNNGNNATGCAGTCGAGCGGATGAGAAGAGCTTGCTCTTCGATTCAGCGGCGGACGGGTGAGTAATG
CCTAGGAATCTGCCTGGTAGTGGGGGACAACGTTTCGAAAGGAACGCTAATACCGCATACGTCCTACGGGAGAAAGCAGG GGACCTTCGGGCCTTGCGCTATCAGATGAGCCTAGGTCGGATTAGCTAGTTGGTGGGGTAATGGCTCACCAAGGCGACGA TCCGTAACTGGTCTGAGAGGATGATCAGTCACACTGGAACTGAGACACGGTCCAGACTCCTACGGGAGGCAGCAGTGGGG AATATTGGACAATGGGCGAAAGCCTGATCCAGCCATGCCGCGTGTGTGAAGAAGGTCTTCGGATTGTAAAGCACTTTAAG TTGGGAGGAAGGGCAGTAAGCGAATACCTTGCTGTTTTGACGTTACCGACAGAATAAGCACCGGCTAACTCTGTGCCAGC AGCCGCGGTAATACAGAGGGTGCAAGCGTTAATCGGAATTACTGGGCGTAAAGCGCGCGTAGGTGGTTTGTTAAGTTGAA TGTGAAAGCCCCGGGCTCAACCTGGGAACTGCATCCAAAACTGGCAAGCTAGAGTACGGTAGAGGGTGGGTGGAATTTCC TGTGTAGCGGTGAAATGCGTAGATATAGGAAGGAACACCAGTGGCGAAGGCGACCACCTGGACTGATACTGACACTGAGG TGCGAAAGCGTGGGGAGCAAACAGGATTAGATACCCTGGTAGTCCACGCCGTANCGATGTCAACTAGCCGTTGGAATCCT TGAGATTTTAGTGGCGCAGCTACGCATTAAGTTGACCGCCTGGGGAGTACGGCCGCAAGGTTAAAACTCANTGAATTGAC GGGGGCCCGCACAAGCGGTGGAGCATGTGGTTTAATTCGAAGCAACGCGANAACCTTACCNNCCTTGACATGCAGANAAC TTTCTAGAGATAGATTGGTGCCTTCNGGAACTCTGACACNNTGCTGCATGGCTGTCGTCAGCTCGTGTCNTGAGATGTTG GGNNAGTCCCGTANNAGCGCAACCCNTGTCCNTANTTACCAGCNCGTTATGGTGGGNACNNNTANNNNACTNCN
Sequence Results Pseudomonas putida, gram negative, often found in soil or water environments.
Though the samples that were sent from the most current experiment did not yield any results, one of the samples from the serial dilutions/agar plates was gram negative, and transect #4 can be best described as a pond habitat, which makes it likely that Pseudomonas putida is present currently.
- Allen D. Irving 19:06, 10 March 2016 (EST):
Identifying Invertebrates and Transect Vertebrate Analysis
Purpose
The purpose of this experiment is to find, identify, and classify invertebrates from a Berlese funnel. The found organisms are then viewed under a dissection scope or microscope, depending on their size. From the information that was previously gathered from the transect in prior experiments, predictions about the various vertebrates that may inhabit the transect. Also, this lab has per-constructed slides to help show invertebrates that are acolomates, have a pseudocoelom, and ones that have a full coelomate or fluid-filled cavity that lines the outside of the digestive tract.
Materials and Methods
The Berlese funnel that was set up in the previous lab using some dirt and leaf litter from the transect is disassembled, and the 50% ethanol containing some of the invertebrates and debris is poured into a dissection dish; multiple dishes may be needed, depending on the volume of ethanol used. Each of the samples are observed under the dissection scope in order to find any possible invertebrates that may be in them. When one is located, a provided dichotomous key can be used in order to help identify the phylum and class of the animal. The invertebrates found are also measured, described by their general morphology, and counted to measured the concentration of a particular organism in the samples.
Five example organisms are also laid out, each representing the five major classes of arthropods; arachnida, diplopoda, chilopoda, insect, and crustacea. Along with arthropod examples are cross-section slides of organisms that are acoelomate, pseudocoelom, and coelomate in order to help visualize the difference in development between the phylum that comprise invertebrates.
Data
Invertebrate #1: The first invertebrate found in one of the samples from the Burlese funnel was an Arachnid from the Arthropoda. It measured roughly 2 mm in length with a pronounced thorax, small abdomen, and other characteristics that are common for a spider. Only one was found in all of the samples taken from the Burlese funnel, and this invertebrate was the largest of all of the specimens found.
Invertebrate #2:
The second species found fell under the class Insecta and the phylum Arthropoda. Much smaller than the first invertebrate observed, this specimen measure ~0.25 mm. There were two in this particular sample, and had an overall oval shape with a very large thorax compared to its head. The legs were laterally compressed towards the front of its body, and the animal was identified as a flea with the use of the dichotomous key.
Invertebrate #3:
The third, and last, animal found in the samples from the funnel was difficult to identify. Being the smallest of the invertebrates observed, with a total body length of ~ 0.20 mm, it did not exhibit any distinguishable characteristics that could be used with a dichotomous key. The invertebrate had six legs evenly distributed on it's body, with two pronounced feelers or antennae on the front near the mouth. The conclusion was that the animal was some type of mite, though its specifics (phylum, class, and order) were never fully understood.
Something to note is that from the three total samples taken from the Burlese funnel, only the sample that was taken from the bottom most portion of the ethanol contained any invertebrates. It is possible that this occurred because the dirt and debris was usually larger than the animals, and could have dragged them to the bottom of the tube containing the ethanol.
The lack of invertebrates could be do to human error in obtaining the samples from the transect, setting up the funnel, or retrieving the ethanol containing the animals.
A few possible vertebrates that would be present in this transect would include squirrels, pigeons, robins, chipmunks, and dogs. The tree dwelling/inhabiting animals such as the squirrels, pigeons, robins, and chipmunks can use the large trees surrounding the transect as a place for shelter and food. The pigeon and robin specifically can also use the dormitory that runs along the side of the transect as a another area to perch and potentially nest. The presence of dogs can be surmised by the co-occurring presence of humans. People who have dogs and live in the neighborhoods around the school could take their pet for a walk, and find the man-made relaxation area that is this particular transect.
- Allen D. Irving 09:02, 19 February 2016 (EST):
Transect Plant and Fungi Analysis
Purpose
For this lab, five different plants were collect from the assigned transect so that characterized and identified as either being monocot or dicot. The plants were viewed under a dissection scope in order to better see the stoma, vascularity patterns, and any other aspects of the plants that would be difficult to see with the naked eye. The purpose was to better understand the structure of the various plants in the transect, as well as their particular method of reproduction. Different types of fungi were also observed under the dissection scope, where their physical structures could be more easily seen, especially the specific spores of the Rhizopus stolonifera, aka Black Bread Mold.
Materials and Methods
Five different plants were collected from various areas of the transect. A key which depicts the various physical differences between monocot and dicot plants was used to aid in identification. Leaf litter and various organic debris was collected in order to set up a Berlese Funnel for the next lab. Rulers and dissection scopes further helped the identification process, allowing for the measurement and of the roots, and a better view of the plants external structures. Then, cross-sections were taken of the plants and their flowers, if they had any, and viewed under a dissection scope, showing a relative view of the cuticle, upper epidermis, mesophylls, and the lower epidermis. Pictures were taken throughout. Seeds were difficult to find at this time of year, however the flowers of several plants were dissected in order to obtain some information about the respective plants reproduction method, which was then used as another factor in identifying the sample as mono- or dicot. Lastly, samples of several types of fungi were set up and overserved, including a cross section of a mushroom and a petri dish containing Black Bread Mold. With prior knowledge of the purpose of Fungi, the observations were used to extrapolate the functions of the Fungi and their importance in various ecosystems.
Data and Discussion
Plant #1:
This plant grows close the ground, near one of the far edges of the transect. This plant has roughly two to three groups of stems and leaves. A distinctive structure is the a single, red stem separates into three more stems, each containing one leaf at the end. The three stems each form a ~90 degree angle with each other. Each of the leaves were about 5 cm long, and the vascular structures on them were net-like, showing that is plant is more than a likely dicot.

Plant #2:
The plant grows behind one of the benches in the transect, in one large plot of land cover roughly 3ft x 4ft. The total height of this particular plant is very short, with the root length = 5cm and the leaf length = 5.4cm; because of this, the plant grows very close to the ground. The leaves themselves are fairly long and thin, and have a parallel vascular system. There was also very little to no stem, where there was no real transition from root to leaf. This plant was identified to be monocot.
Plant #3:
This plant is a large shrub running alongside the outside of the dormitory next to the transect. There are four of these shrubs in the transect currently. The plant is tall, standing at a relative 2 feet and the leaf length of the plant = 11cm. These leaves in particular had a very thick cuticle, giving them a waxy texture. A net-like vascular system was apparent on the leaves, giving evidence to this plant being dicot. A flower bud was also taken from this plant, which gave some information on this plant’s method of reproduction. The cross section of the bud showed a large amount of filaments, as well as a grouping of style leading into the ovary of the bud.

Plant #4:
This sample grows in several spots around the koi pond, located in the center of the transect. The leaves for this plant were very long and thin, reaching an average length of 30cm. About seven to ten groups of these plants grow within the areas around the pond. The cuticle is very thick on both sides; the most likely reason being that the leaves blow around in the wind and become turned over. The thick waxy layer on both sides allows for greater protection of the stoma. The vascular system for this plant was parallel, meaning that is it mostly likely monocot.

Plant #5: There are not many grouping of this plant in the transect, with around four to six total around the benches. The leaves are short and relatively stubby, with a small, white bud growing from the top of one of the leaves. The stems reach far into the ground, relative to the leaf length; 6cm and 3cm respectively. A cross section of the bud yielded similar results to Plant #3, where some filaments and pollen where evident when looked at under the dissection scope. The veins of the leaves had a parallel pattern, showing that this plant is monocot.
Fungi sporangia are where the spore of fungi (and some plants) are formed. These sporangia are the location where mitosis and meiosis can occur, depending on the reproductive cycle that the fungi are in. They are located at either the tip of the stem, or can be found running on the side of the stem of a plant or fungi. This structure is crucial for the protection of the spores, and allows for the segregation of spores if the fungi is hetersporous, in order to avoid self pollination.
One of the fungi observed under the dissection scope was the Black Bread Mold, and falls into the asocomycota group of fungi.
Discussion
Many of the plants found in the transect were small and laid very low to the ground. The only exceptions to this were the shrubberies and a few tall trees that lined a portion of the transect. The reason why many of the the plants grew so close to the ground can be because it is a man-made area that receives constant care and watering, as well as there is ample room for sun light. Though the trees provide significant shade in the spring and summer, there position does not lead to diminished sun light in the areas where the plants are growing. Since there is not a method of evolution that has made the trait of growing low to the ground hazardous for the various populations existence, they are able to thrive.
- Allen D. Irving 18:29, 10 February 2016 (EST):
Identifying Bacteria and Microbiology
Purpose
For this lab, the transect sample was observed on final time and the changes from last week’s lab were noted, and a hypothesis was made as to why the changes occur. Then, the agar plates that used the serial dilutions, both with and without tetracycline were inspected for the number of colonies, as well as the characteristics of the cells in the colonies, including their morphology and method of motility. Gram stains were prepared in order to determine whether or not the bacteria were gram positive or gram negative, and a PCR sample was take in order to determine a specific culture’s 16s rRNA gene.
Materials and Methods
The eight serial dilution results on the agar plates, with four of them contain tetracycline, are observed. The concentration of the dilution decreases from 10-3 to 10-9. Next, the number of colonies per mL is calculated using the conversation factors; 103 for the first dilution, 105 for the second, etc. Wet mounts are made using four separate colonies, with two coming from the non-tetracycline plates and two coming from the agar treated with tet. Observe each sample and take note of the shape of the bacteria, the type of motility they use (cilia or flagella), and note any other outstanding observations. The gram stain process involves a sample from one of the chosen colonies. The prepared slide is washed liberally with crystal violet, Gram’s iodine mordant, 95% alcohol, and safranin stain, with flooding of water between each of these staining processes. The slides are then observed under a microscope in order to determine whether the culture is gram positive or gram negative.
Data and Discussion
The final Hay Infusion observation revealed that the rancid smell had all but disappeared, and the viscous layer was mostly gone. The middle portion had become slightly see through, with various detritus spread on the bottom of the jar.
When counting up the number of colonies on the eight agar plates, it was clear that many more colonies of bacteria had grown on the plates that only contained nutrient agar. The least diluted, 10-3 sample contained roughly 5,900 colonies on the plate, with that number decreasing to 59 on the next least diluted sample. The final two plate only containing the agar had one colony each. Though considerably less, the least diluted agar plate had 61 colonies throughout, with the number of colonies decreasing to 1 on the 10-5 dilution, and zero for the final two. The least dilution plate with tet mostly grew semi-large, round, yellow colonies with a polvinate ridge, whereas the 10-3 agar had many small colonies and were mostly white and yellow in color.
Image 2: Non-tetracycline sample 10^-3
Image 3: Non-tetracycline sample 10^-5
Image 4: Non-tetracycline sample 10^-7

Image 5: Tetracycline sample 10^-3

[[ Gram Negative]]
Image 6: 10^-3 non-tetracycline

Image 7: 10^-5 non-tetracycline

Image 8: 10^-3 Tetracycline yellow

Image 9: 10^-3 Tetracycline white

The non-tet plates where mostly comprised of motile, coccobacillus bacteria and non-motile coccus bacteria. The tet agar plates had some more variety, containing motile coccus, bacillus, and filament shaped bacteria. The four colonies that were observed in this way and stained were two white cultures from the non-tet containing plates, one from the 10-3 dilution and one from the 10-5. The tet containing samples were both taken from the 10-3 plate, where one sample came from a white colony, and one came from a yellow colony. All of the cultures, with exception to the white, tet containing colony, came back as gram negative.
- Allen D. Irving 23:31, 3 February 2016 (EST):
Hay Infusion Observation and Serial Dilutions 1/21/16
Purpose
The Hay Infusions that were made the previous week from the transect materials was observed to identify a possible niches that exist within the jar. Samples were also seen through a microscope in an attempt to identify many of the organisms alive in the various parts of the Infusion.
Materials and Methods
Several slides were made using samples from the top, middle, and bottom portions of the Hay Infusion via a pipette. The various organisms, both protists and algae, where observed and noted using a Dichotomous Key as a reference point.
Data and Observations
From the samples taken from the Hay Infusion, only the middle and bottom niches showed any significant forms of life. The top niche was covered in a viscous, mold like layer, though no significant biotic activity was present. In the middle niche, there were many protists, including paranema. Others were more difficult to identify, though some disguising features of these other protists include prominent oral fissures and differing movement patterns, dependent on their quantity of cilia or the presence of a flagella. For algae, though it was difficult in determining the exact species with using the Key, one notable observation was the appearance of some Rhodophyta.
Conclusions and Discussions An interesting outcome from observing the Hay Infusion was that the top, surface portion was covered in a moldy covering with plenty of organic material that could potentially be used as food. One possibility is that this thick layer created a sort of semi-aerobic environment, shielding the niches below from possible disruptive debris or airflow, while providing a constant source of nutrients from the material stuck at the top. If the Infusion was left out for one to two months, something that may happen would be an initial explosion of species that were present when the Infusion was made, then a gradual decline in overall populations due to the finite resources available in the jar. That said, what may be observed would be a significant density in a few populations.
- Allen D. Irving 21:14, 27 January 2016 (EST):
Examining Biological Life at AU
The transect that was observed is positioned by Roper Hall and consists of a koi pond surrounded by stones, three benches, a slight variety of tall and short grasses, two fully developed trees, one sapling, and three large shrubs. The entire area is mostly man-made, with flat stones arranged for a walking path and the vegetation has been purposefully planted in specific spots. Some organic life was present at the time of the observations, namely squirrels living in one of the larger trees.
File:Scanned Terasect Image.pdf
- Allen Irving: 1/20/16










